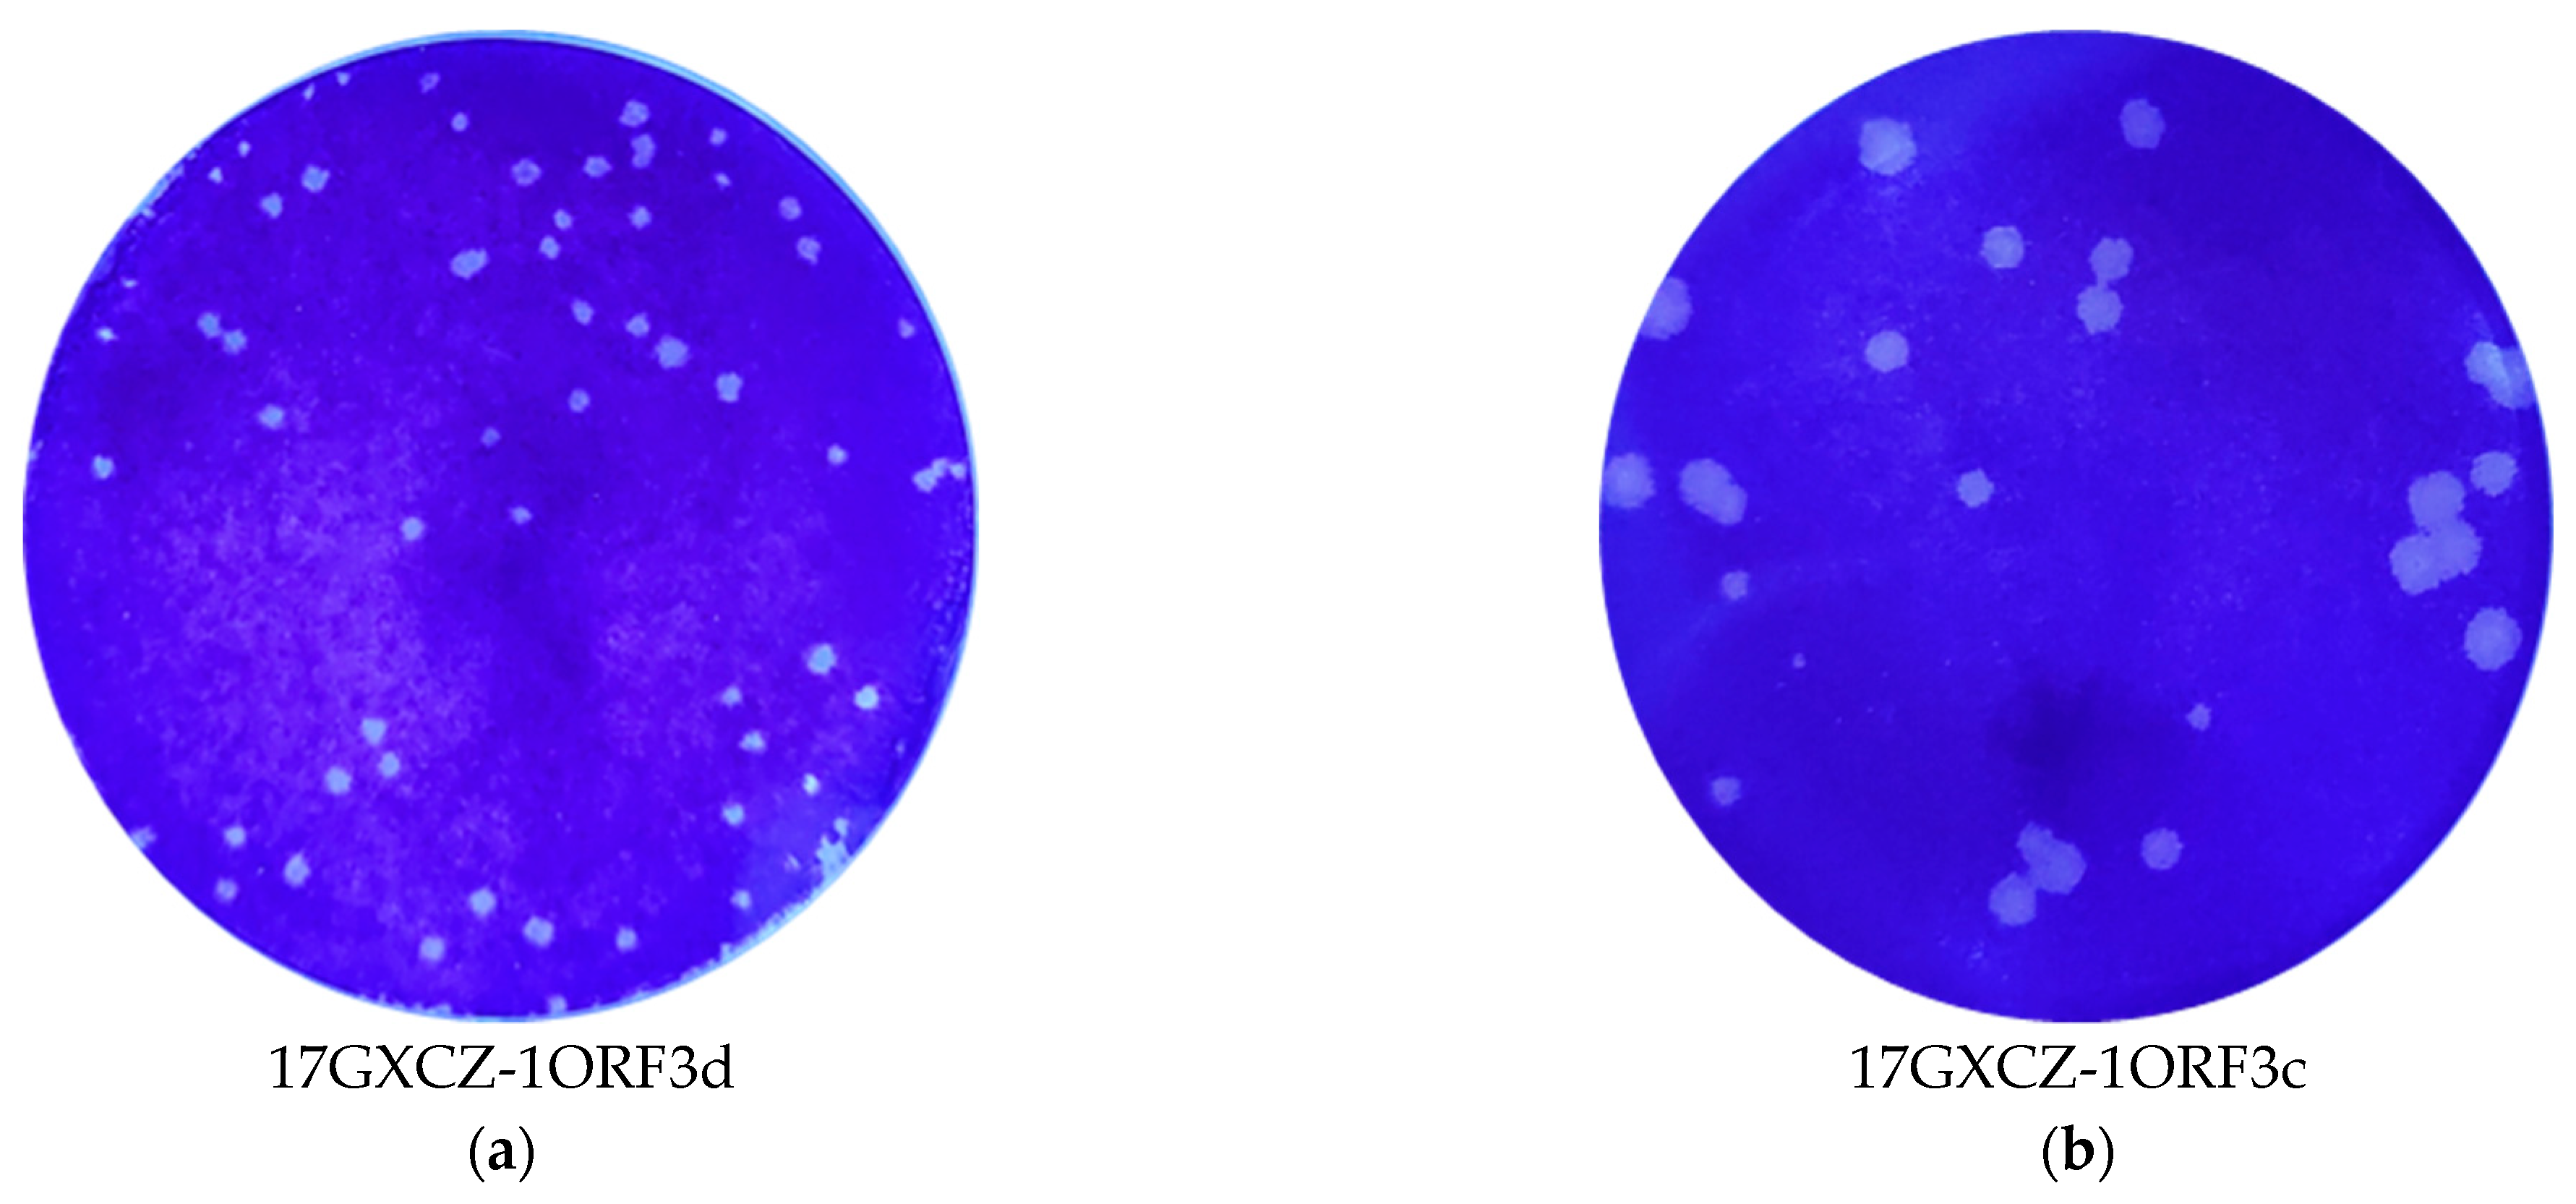
Viruses 13 01562 g002a

Comparative Characterization and Pathogenicity of a Novel Porcine Epidemic Diarrhea Virus (PEDV) with a Naturally Occurring Truncated ORF3 Gene Coinfected with PEDVs Possessing an Intact ORF3 Gene in Piglets
Abstract
:1. Introduction
2. Materials and Methods
2.1. Sample Collection
2.2. PEDV Diagnosis and ORF3 Amplification
2.3. PEDV Isolation and Purification
2.4. Indirect Immunofluorescence Assay
2.5. Multi-Step Growth Curves of Viruses
2.6. Whole Genome Sequencing of PEDV
2.7. Multiple Alignments and Phylogenetic Analyses
2.8. Experimental Design of Infection
2.9. H&E and IHC Staining
2.10. Statistical Analysis
3. Results
3.1. Virus Isolation and Biological Characteristics of 17GXCZ-1ORF3d and 17GXCZ-1ORF3c Strains In Vitro
3.2. Full-Length Genome Sequence Analysis and Phylogenetic Characterization of PEDV 17GXCZ-1ORF3d and 17GXCZ-1ORF3c Strains
3.3. Pathogenicity of 17GXCZ-1ORF3d and 17GXCZ-1ORF3c Strains in Piglets
4. Discussion
5. Conclusions
Supplementary Materials
Author Contributions
Funding
Institutional Review Board Statement
Data Availability Statement
Acknowledgments
Conflicts of Interest
References
- Chen, P.; Wang, K.; Hou, Y.; Li, H.; Li, X.; Yu, L.; Jiang, Y.; Gao, F.; Tong, W.; Yu, H.; et al. Genetic evolution analysis and pathogenicity assessment of porcine epidemic diarrhea virus strains circulating in part of China during 2011–2017. Infect. Genet. Evol. J. Mol. Epidemiol. Evol. Genet. Infect. Dis. 2019, 69, 153–165. [Google Scholar] [CrossRef]
- Lin, C.M.; Saif, L.J.; Marthaler, D.; Wang, Q. Evolution, antigenicity and pathogenicity of global porcine epidemic diarrhea virus strains. Virus Res. 2016, 226, 20–39. [Google Scholar] [CrossRef] [Green Version]
- Jung, K.; Saif, L.J. Porcine epidemic diarrhea virus infection: Etiology, epidemiology, pathogenesis and immunoprophylaxis. Vet. J. 2015, 204, 134–143. [Google Scholar] [CrossRef]
- Li, W.; Li, H.; Liu, Y.; Pan, Y.; Deng, F.; Song, Y.; Tang, X.; He, Q. New variants of porcine epidemic diarrhea virus, China, 2011. Emerg. Infect. Dis. 2012, 18, 1350–1353. [Google Scholar] [CrossRef] [PubMed]
- Sun, R.Q.; Cai, R.J.; Chen, Y.Q.; Liang, P.S.; Chen, D.K.; Song, C.X. Outbreak of porcine epidemic diarrhea in suckling piglets, China. Emerg. Infect. Dis. 2012, 18, 161–163. [Google Scholar] [CrossRef]
- Jung, K.; Wang, Q.; Scheuer, K.A.; Lu, Z.; Zhang, Y.; Saif, L.J. Pathology of US porcine epidemic diarrhea virus strain PC21A in gnotobiotic pigs. Emerg. Infect. Dis. 2014, 20, 662–665. [Google Scholar] [CrossRef]
- Boniotti, M.B.; Papetti, A.; Lavazza, A.; Alborali, G.; Sozzi, E.; Chiapponi, C.; Faccini, S.; Bonilauri, P.; Cordioli, P.; Marthaler, D. Porcine Epidemic Diarrhea Virus and Discovery of a Recombinant Swine Enteric Coronavirus, Italy. Emerg. Infect. Dis. 2016, 22, 83–87. [Google Scholar] [CrossRef] [PubMed]
- Suzuki, T.; Murakami, S.; Takahashi, O.; Kodera, A.; Masuda, T.; Itoh, S.; Miyazaki, A.; Ohashi, S.; Tsutsui, T. Molecular characterization of pig epidemic diarrhoea viruses isolated in Japan from 2013 to 2014. Infect. Genet. Evol. J. Mol. Epidemiol. Evol. Genet. Infect. Dis. 2015, 36, 363–368. [Google Scholar] [CrossRef] [PubMed]
- Lin, C.M.; Ghimire, S.; Hou, Y.; Boley, P.; Langel, S.N.; Vlasova, A.N.; Saif, L.J.; Wang, Q. Pathogenicity and immunogenicity of attenuated porcine epidemic diarrhea virus PC22A strain in conventional weaned pigs. BMC Vet. Res. 2019, 15, 26. [Google Scholar] [CrossRef] [PubMed] [Green Version]
- Deng, F.; Ye, G.; Liu, Q.; Navid, M.T.; Zhong, X.; Li, Y.; Wan, C.; Xiao, S.; He, Q.; Fu, Z.F.; et al. Identification and Comparison of Receptor Binding Characteristics of the Spike Protein of Two Porcine Epidemic Diarrhea Virus Strains. Viruses 2016, 8, 55. [Google Scholar] [CrossRef] [Green Version]
- Li, W.; van Kuppeveld, F.J.M.; He, Q.; Rottier, P.J.M.; Bosch, B.J. Cellular entry of the porcine epidemic diarrhea virus. Virus Res. 2016, 226, 117–127. [Google Scholar] [CrossRef] [PubMed] [Green Version]
- Chen, J.; Liu, X.; Shi, D.; Shi, H.; Zhang, X.; Li, C.; Chi, Y.; Feng, L. Detection and molecular diversity of spike gene of porcine epidemic diarrhea virus in China. Viruses 2013, 5, 2601–2613. [Google Scholar] [CrossRef] [Green Version]
- Guo, J.; Fang, L.; Ye, X.; Chen, J.; Xu, S.; Zhu, X.; Miao, Y.; Wang, D.; Xiao, S. Evolutionary and genotypic analyses of global porcine epidemic diarrhea virus strains. Transbound. Emerg. Dis. 2019, 66, 111–118. [Google Scholar] [CrossRef] [PubMed] [Green Version]
- Kaewborisuth, C.; He, Q.; Jongkaewwattana, A. The Accessory Protein ORF3 Contributes to Porcine Epidemic Diarrhea Virus Replication by Direct Binding to the Spike Protein. Viruses 2018, 10, 399. [Google Scholar] [CrossRef] [PubMed] [Green Version]
- Si, F.; Hu, X.; Wang, C.; Chen, B.; Wang, R.; Dong, S.; Yu, R.; Li, Z. Porcine Epidemic Diarrhea Virus (PEDV) ORF3 Enhances Viral Proliferation by Inhibiting Apoptosis of Infected Cells. Viruses 2020, 12, 214. [Google Scholar] [CrossRef] [Green Version]
- Wang, K.; Lu, W.; Chen, J.; Xie, S.; Shi, H.; Hsu, H.; Yu, W.; Xu, K.; Bian, C.; Fischer, W.B.; et al. PEDV ORF3 encodes an ion channel protein and regulates virus production. FEBS Lett. 2012, 586, 384–391. [Google Scholar] [CrossRef] [Green Version]
- Park, S.J.; Moon, H.J.; Luo, Y.; Kim, H.K.; Kim, E.M.; Yang, J.S.; Song, D.S.; Kang, B.K.; Lee, C.S.; Park, B.K. Cloning and further sequence analysis of the ORF3 gene of wild- and attenuated-type porcine epidemic diarrhea viruses. Virus Genes 2008, 36, 95–104. [Google Scholar] [CrossRef]
- Chen, J.; Wang, C.; Shi, H.; Qiu, H.; Liu, S.; Chen, X.; Zhang, Z.; Feng, L. Molecular epidemiology of porcine epidemic diarrhea virus in China. Arch. Virol. 2010, 155, 1471–1476. [Google Scholar] [CrossRef]
- Su, M.; Li, C.; Qi, S.; Yang, D.; Jiang, N.; Yin, B.; Guo, D.; Kong, F.; Yuan, D.; Feng, L.; et al. A molecular epidemiological investigation of PEDV in China: Characterization of co-infection and genetic diversity of S1-based genes. Transbound. Emerg. Dis. 2020, 67, 1129–1140. [Google Scholar] [CrossRef] [Green Version]
- Van Diep, N.; Norimine, J.; Sueyoshi, M.; Lan, N.T.; Yamaguchi, R. Novel Porcine Epidemic Diarrhea Virus (PEDV) Variants with Large Deletions in the Spike (S) Gene Coexist with PEDV Strains Possessing an Intact S Gene in Domestic Pigs in Japan: A New Disease Situation. PLoS ONE 2017, 12, e0170126. [Google Scholar]
- Van Diep, N.; Choijookhuu, N.; Fuke, N.; Myint, O.; Izzati, U.Z.; Suwanruengsri, M.; Hishikawa, Y.; Yamaguchi, R. New tropisms of porcine epidemic diarrhoea virus (PEDV) in pigs naturally coinfected by variants bearing large deletions in the spike (S) protein and PEDVs possessing an intact S protein. Transbound. Emerg. Dis. 2020, 67, 2589–2601. [Google Scholar] [CrossRef] [PubMed]
- Su, Y.; Hou, Y.; Wang, Q. The enhanced replication of an S-intact PEDV during coinfection with an S1 NTD-del PEDV in piglets. Vet. Microbiol. 2019, 228, 202–212. [Google Scholar] [CrossRef]
- Su, Y.; Hou, Y.; Prarat, M.; Zhang, Y.; Wang, Q. New variants of porcine epidemic diarrhea virus with large deletions in the spike protein, identified in the United States, 2016–2017. Arch. Virol. 2018, 163, 2485–2489. [Google Scholar] [CrossRef] [PubMed]
- Huan, C.; Pan, H.; Fu, S.; Xu, W.; Gao, Q.; Wang, X.; Gao, S.; Chen, C.; Liu, X. Characterization and evolution of the coronavirus porcine epidemic diarrhoea virus HLJBY isolated in China. Transbound. Emerg. Dis. 2020, 67, 65–79. [Google Scholar] [CrossRef] [PubMed] [Green Version]
- Lu, Y.; Su, X.; Du, C.; Mo, L.; Ke, P.; Wang, R.; Zhong, L.; Yang, C.; Chen, Y.; Wei, Z.; et al. Genetic Diversity of Porcine Epidemic Diarrhea Virus With a Naturally Occurring Truncated ORF3 Gene Found in Guangxi, China. Front. Vet. Sci. 2020, 7, 435. [Google Scholar] [CrossRef] [PubMed]
- Li, J.; Jin, Z.; Gao, Y.; Zhou, L.; Ge, X.; Guo, X.; Han, J.; Yang, H. Development of the full-length cDNA clones of two porcine epidemic diarrhea disease virus isolates with different virulence. PLoS ONE 2017, 12, e0173998. [Google Scholar] [CrossRef]
- Oka, T.; Saif, L.J.; Marthaler, D.; Esseili, M.A.; Meulia, T.; Lin, C.M.; Vlasova, A.N.; Jung, K.; Zhang, Y.; Wang, Q. Cell culture isolation and sequence analysis of genetically diverse US porcine epidemic diarrhea virus strains including a novel strain with a large deletion in the spike gene. Vet. Microbiol. 2014, 173, 258–269. [Google Scholar] [CrossRef]
- Tian, Y.; Yang, X.; Li, H.; Ma, B.; Guan, R.; Yang, J.; Chen, D.; Han, X.; Zhou, L.; Song, Z.; et al. Molecular characterization of porcine epidemic diarrhea virus associated with outbreaks in southwest China during 2014-2018. Transbound. Emerg. Dis. 2020. [Google Scholar] [CrossRef]
- Li, F. Structure, Function, and Evolution of Coronavirus Spike Proteins. Annu. Rev. Virol. 2016, 3, 237–261. [Google Scholar] [CrossRef] [PubMed] [Green Version]
- Li, W.; Wicht, O.; van Kuppeveld, F.J.; He, Q.; Rottier, P.J.; Bosch, B.J. A Single Point Mutation Creating a Furin Cleavage Site in the Spike Protein Renders Porcine Epidemic Diarrhea Coronavirus Trypsin Independent for Cell Entry and Fusion. J. Virol. 2015, 89, 8077–8081. [Google Scholar] [CrossRef] [PubMed] [Green Version]
- Tan, Y.; Sun, L.; Wang, G.; Shi, Y.; Dong, W.; Fu, Y.; Fu, Z.; Chen, H.; Peng, G. The trypsin-enhanced infection of porcine epidemic diarrhea virus is determined by the S2 subunit of the spike glycoprotein. J. Virol. 2021, 95, e02453-20. [Google Scholar] [CrossRef] [PubMed]
- Kaewborisuth, C.; Yingchutrakul, Y.; Roytrakul, S.; Jongkaewwattana, A. Porcine Epidemic Diarrhea Virus (PEDV) ORF3 Interactome Reveals Inhibition of Virus Replication by Cellular VPS36 Protein. Viruses 2019, 11, 382. [Google Scholar] [CrossRef] [Green Version]
- Song, D.S.; Yang, J.S.; Oh, J.S.; Han, J.H.; Park, B.K. Differentiation of a Vero cell adapted porcine epidemic diarrhea virus from Korean field strains by restriction fragment length polymorphism analysis of ORF 3. Vaccine 2003, 21, 1833–1842. [Google Scholar] [CrossRef]
- Zou, D.; Xu, J.; Duan, X.; Xu, X.; Li, P.; Cheng, L.; Zheng, L.; Li, X.; Zhang, Y.; Wang, X.; et al. Porcine epidemic diarrhea virus ORF3 protein causes endoplasmic reticulum stress to facilitate autophagy. Vet. Microbiol. 2019, 235, 209–219. [Google Scholar] [CrossRef] [PubMed]
- Zhang, Q.; Shi, K.; Yoo, D. Suppression of type I interferon production by porcine epidemic diarrhea virus and degradation of CREB-binding protein by nsp1. Virology 2016, 489, 252–268. [Google Scholar] [CrossRef] [PubMed] [Green Version]
- Wu, Z.; Cheng, L.; Xu, J.; Li, P.; Li, X.; Zou, D.; Zhang, Y.; Wang, X.; Wu, X.; Shen, Y.; et al. The accessory protein ORF3 of porcine epidemic diarrhea virus inhibits cellular interleukin-6 and interleukin-8 productions by blocking the nuclear factor-kappaB p65 activation. Vet. Microbiol. 2020, 251, 108892. [Google Scholar] [CrossRef]
- Beall, A.; Yount, B.; Lin, C.M.; Hou, Y.; Wang, Q.; Saif, L.; Baric, R. Characterization of a Pathogenic Full-Length cDNA Clone and Transmission Model for Porcine Epidemic Diarrhea Virus Strain PC22A. mBio 2016, 7, e01451-15. [Google Scholar] [CrossRef] [Green Version]
- Jung, K.; Saif, L.J.; Wang, Q. Porcine epidemic diarrhea virus (PEDV): An update on etiology, transmission, pathogenesis, and prevention and control. Virus Res. 2020, 286, 198045. [Google Scholar] [CrossRef]
- Chen, Q.; Gauger, P.C.; Stafne, M.R.; Thomas, J.T.; Madson, D.M.; Huang, H.; Zheng, Y.; Li, G.; Zhang, J. Pathogenesis comparison between the United States porcine epidemic diarrhoea virus prototype and S-INDEL-variant strains in conventional neonatal piglets. J. Gen. Virol. 2016, 97, 1107–1121. [Google Scholar] [CrossRef] [Green Version]
- Lin, C.M.; Annamalai, T.; Liu, X.; Gao, X.; Lu, Z.; El-Tholoth, M.; Hu, H.; Saif, L.J.; Wang, Q. Experimental infection of a US spike-insertion deletion porcine epidemic diarrhea virus in conventional nursing piglets and cross-protection to the original US PEDV infection. Vet. Res. 2015, 46, 134. [Google Scholar] [CrossRef] [PubMed] [Green Version]
- Jung, K.; Miyazaki, A.; Saif, L.J. Immunohistochemical detection of the vomiting-inducing monoamine neurotransmitter serotonin and enterochromaffin cells in the intestines of conventional or gnotobiotic (Gn) pigs infected with porcine epidemic diarrhea virus (PEDV) and serum cytokine responses of Gn pigs to acute PEDV infection. Res. Vet. Sci. 2018, 119, 99–108. [Google Scholar] [PubMed]
- Teeravechyan, S.; Frantz, P.N.; Wongthida, P.; Chailangkarn, T.; Jaru-Ampornpan, P.; Koonpaew, S.; Jongkaewwattana, A. Deciphering the biology of porcine epidemic diarrhea virus in the era of reverse genetics. Virus Res. 2016, 226, 152–171. [Google Scholar] [CrossRef]
- Chen, X.; Zeng, L.; Yang, J.; Yu, F.; Ge, J.; Guo, Q.; Gao, X.; Song, T. Sequence heterogeneity of the ORF3 gene of porcine epidemic diarrhea viruses field samples in Fujian, China, 2010–2012. Viruses 2013, 5, 2375–2383. [Google Scholar] [CrossRef] [PubMed]
- Chen, F.; Zhu, Y.; Wu, M.; Ku, X.; Ye, S.; Li, Z.; Guo, X.; He, Q. Comparative Genomic Analysis of Classical and Variant Virulent Parental/Attenuated Strains of Porcine Epidemic Diarrhea Virus. Viruses 2015, 7, 5525–5538. [Google Scholar] [CrossRef] [PubMed]
- Wongthida, P.; Liwnaree, B.; Wanasen, N.; Narkpuk, J.; Jongkaewwattana, A. The role of ORF3 accessory protein in replication of cell-adapted porcine epidemic diarrhea virus (PEDV). Arch. Virol. 2017, 162, 2553–2563. [Google Scholar] [CrossRef] [PubMed]

| Gene | 17GXCZ-1ORF3d (MT547179) | 17GXCZ-1ORF3c (MT547180) | CV777 (AF353511) | AJ1102 (JX188454) | ||||
|---|---|---|---|---|---|---|---|---|
| Size (nt) | Size (aa) | Size (nt) | Identity (%) | Size (nt) | Identity (%) | Size (nt) | Identity (%) | |
| 5′UTR | 292 | / | 292 | 100 | 296 | 97.3 | 292 | 98.6 |
| ORF1a/1b | 20,345 | 6781 | 20,345 | 100 | 20,345 | 97.2 | 20,344 | 98.4 |
| S | 4158 | 1386 | 4158 | 99.9 | 4152 | 94.1 | 4158 | 97.9 |
| ORF3 | 293 | 89 | 675 | 80.5 | 675 | 78.1 | 675 | 79.5 |
| E | 231 | 76 | 231 | 99.1 | 231 | 97.4 | 231 | 99.6 |
| M | 681 | 226 | 681 | 99.7 | 681 | 98.4 | 681 | 99.4 |
| N | 1326 | 441 | 1326 | 100 | 1326 | 95.9 | 1326 | 97.7 |
| 3′UTR | 334 | / | 334 | 100 | 334 | 95.8 | 343 | 98.2 |
| Total | 27,662 | / | 28,044 | 99.9 | 28,033 | 96.7 | 28,044 | 98.3 |
| Groups | Inoculum Dose (2 mL) | Mortality | Fecal Shedding, Log10 Copies/mL, by PIH, Mean | Onset of Clinical Signs as Judged by PIH | Quantification of Viral Load, Log10 Copies/mL, Mean | VH: CD, Mean | PEDV Antigen Detection in Frozen Tissues ‡ | |||||||||||
|---|---|---|---|---|---|---|---|---|---|---|---|---|---|---|---|---|---|---|
| 0 | 24 | 48 | 72 | 96 | 120 | D | J | I | D | J | I | D | J | I | ||||
| Mock | Cell culture media | 0%, 4/4 | - | - | - | - | - | - | - | - | - | - | 3.32 | 2.44 | 2.86 | - | - | - |
| 17GXCZ-1 ORF3d | 6 log10 PFU/mL | 75%, 1/4 | - | 1.72 | 5.89 | 6.43 | 6.68 | 4.66 | 24-48 | 6.32 | 7.12 | 6.90 | 2.38 * | 1.94 * | 1.96 ** | ++ | +++ | + |
| 17GXCZ-1 ORF3c | 6 log10 PFU/mL | 50%, 2/4 | - | - | 4.94 | 5.76 | 6.43 | 3.46 | 36-48 | 6.18 | 6.42 | 6.87 | 2.32 * | 2.00 | 2.42 * | + | + | ++ |
Publisher’s Note: MDPI stays neutral with regard to jurisdictional claims in published maps and institutional affiliations. |
© 2021 by the authors. Licensee MDPI, Basel, Switzerland. This article is an open access article distributed under the terms and conditions of the Creative Commons Attribution (CC BY) license (https://creativecommons.org/licenses/by/4.0/).
Share and Cite
Lu, Y.; Huang, W.; Zhong, L.; Qin, Y.; Liu, X.; Yang, C.; Wang, R.; Su, X.; Du, C.; Mi, X.; et al. Comparative Characterization and Pathogenicity of a Novel Porcine Epidemic Diarrhea Virus (PEDV) with a Naturally Occurring Truncated ORF3 Gene Coinfected with PEDVs Possessing an Intact ORF3 Gene in Piglets. Viruses 2021, 13, 1562. https://doi.org/10.3390/v13081562
Lu Y, Huang W, Zhong L, Qin Y, Liu X, Yang C, Wang R, Su X, Du C, Mi X, et al. Comparative Characterization and Pathogenicity of a Novel Porcine Epidemic Diarrhea Virus (PEDV) with a Naturally Occurring Truncated ORF3 Gene Coinfected with PEDVs Possessing an Intact ORF3 Gene in Piglets. Viruses. 2021; 13(8):1562. https://doi.org/10.3390/v13081562
Chicago/Turabian StyleLu, Ying, Weijian Huang, Lian Zhong, Yibin Qin, Xueting Liu, Chunjie Yang, Ruomu Wang, Xueli Su, Chen Du, Xue Mi, and et al. 2021. "Comparative Characterization and Pathogenicity of a Novel Porcine Epidemic Diarrhea Virus (PEDV) with a Naturally Occurring Truncated ORF3 Gene Coinfected with PEDVs Possessing an Intact ORF3 Gene in Piglets" Viruses 13, no. 8: 1562. https://doi.org/10.3390/v13081562
APA StyleLu, Y., Huang, W., Zhong, L., Qin, Y., Liu, X., Yang, C., Wang, R., Su, X., Du, C., Mi, X., Wang, H., He, Y., Zhao, W., Chen, Y., Wei, Z., & Ouyang, K. (2021). Comparative Characterization and Pathogenicity of a Novel Porcine Epidemic Diarrhea Virus (PEDV) with a Naturally Occurring Truncated ORF3 Gene Coinfected with PEDVs Possessing an Intact ORF3 Gene in Piglets. Viruses, 13(8), 1562. https://doi.org/10.3390/v13081562

